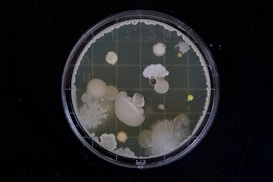
A petri dish containing various colonies of bacteria and fungi, showcasing diverse shapes, sizes, and colors. The colonies are growing on a nutrient agar medium with a grid pattern beneath them. Some colonies are circular and smooth, while others have fringed or filamentous edges. The dish is viewed from above, displaying a layer of translucent medium and different colony morphologies.

Gutsense
Educamos sobre el microbioma intestinal de manera clara y accesible.

Gutsense: Educación
En Gutsense, educamos sobre el microbioma intestinal con un enfoque claro y accesible, ofreciendo recursos visuales y consejos prácticos para tu salud.

Servicios Educativos
Ofrecemos recursos claros sobre el microbioma intestinal y su impacto en la salud.


Galería Educativa
Explora nuestro contenido visual sobre el microbioma intestinal y su impacto en la salud.



Descubre tu microbioma
Aprende sobre el microbioma intestinal y mejora tu salud con consejos accesibles y visuales. ¡Empieza hoy!